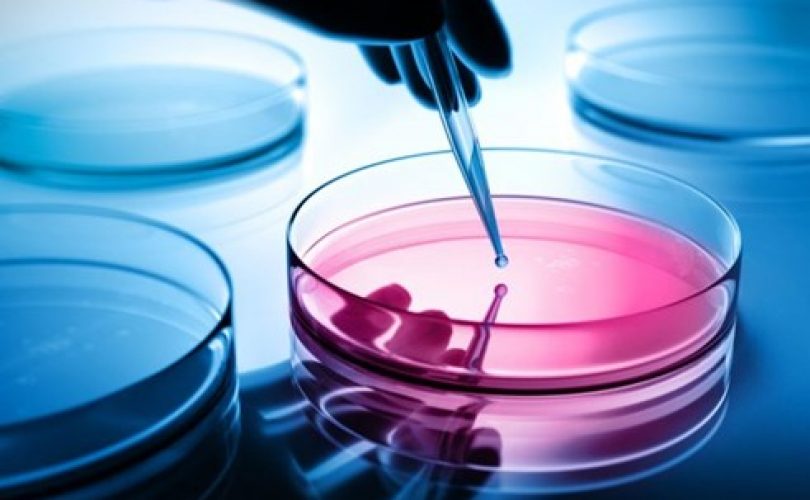

Son Dakika Bilim
Dünyamız bugüne dek hiç olmadığı kadar büyük bir plastik atık sorunu yaşıyor. Bu biraz da tüm plastik atıkların yüzde yirmisinin bile yenilenememesiyle de ilgili. Ama bu konuda karışık plastiğin yeniden değerlendirmeye izin verecek yöntemlerin eksikliği de rol oynuyor. Bununla birlikte artık örneğin mikroplar, enzimler veya özel katalizörlerle plastik atığın indirgendiği ve başka alanlarda kullanı...
Adenovirüsler şu sıralar özellikle de korona aşılarında önemli bir rol oynuyorlar. Nitekim AstraZeneca, Johnson&Johnson veya Rusların Sputnik V aşılarında, viral spike proteininin (diken proteini) yapı planını hücrelerimize aşılamak, için bu soğuk algınlığı virüsünün çeşitli varyantlarından yararlanılıyor. Adenovirüsler öte yandan çeşitli etki maddeleri ve genetik tedaviler için bir taşıyıcı o...
Sadece birkaç milimetre büyüklüğünde ve içi boş olmasına rağmen, ritmik olarak atan mini organ, insan embriyosunda gelişen bir kalbe çok benziyor. Viyana Moleküler Biyoteknoloji Enstitüsü’nden (IMBA) Sasha Mendjan ‘Elimizdeki var olan, insan embriyosunda embriyoda birinci ayın sonunda gelişen sol karıncık. Bu açıdan bakıldığında küçük bir pompa diyebiliriz’ diyor araştırmacı. Daha önceki çalışmala...
Uzmanlar şişmanlık, diyabet, otobağışıklık hastalığı gibi riskleri olan, hamilelik sırasında komplikasyonlar yaşayan ve ailelerinde yüksek tansiyon olan kadınların düzenli olarak tansiyonlarını ölçtürmelerini öneriliyor. Bergen Üniversitesi’nden Ester Kringeland ve ekibi, kadınlarda yüksek tansiyonun erkeklere kıyasla daha yüksek kalp enfarktüsü, inme vb hastalık riskleri oluşturduğuna dayanan ara...
Bakır, prehistorik zamanlardan beri aranan bir hammadde. O tarihlerde bakır, tunç, ziynet ve para gibi ürünlerin temelini oluşturuyordu. Günümüzde ise bakır her şeyden önce iyi bir elektrik ve ısı iletkeni olduğu için elektronik ve teknik için önemli. Bakır, iletkenler, elektromıknatıslar, sensorlar, bakır boru, antibakteriyel kaplama ve alaşım için kullanılıyor. Fakat atomik bakır elde etmek hala...
Bir dürbün, bir kamera ve biraz da sabırla dünya genelinde birçok insan boş vaktini, kuş gözlemek için doğada geçiriyor. 18.yy’dan itibaren İngiltere’de yaygın olan bu hobi, son yıllarda küresel bir trend haline geldi. Dijitalleşme sayesinde gözlemler artık sistematik olarak kaydediliyor. Kuş araştırmacıları artık tüm dünyadaki gözlem verilerine erişebiliyorlar. Bu verilerle örneğin bilinen tüm ku...
Paleontologlar Meksika’da daha önce bilinmeyen bir dinozor türü buldular. Otçul Tlatolophus galorum, oldukça iyi korunagelen kafatası (%80) sayesinde belirlenebildi. Kuzey Meksika’daki Coahuila eyaletindeki kazılarda bulunan kafatasının üzerinde 1,32 metrelik bir tepeliği de bulunuyor. Tlatolophus adı Aztek dili olan Nahuatl’daki Tlahtolli (kelime) ve Yunancadaki Lophus (tarak) sözcüklerinden türe...
Rüzgar türbinleri teorik olarak insanlığın enerji ihtiyacını fazlasıyla karşılayabilir. Sadece Avrupa’da 52 Terawatt kapasiteli rüzgar enerji santralı bunuyor. Ne var ki bu yenilenebilir enerji tesislerinin artırılmasında bazı olumsuzluklar da söz konusu. Rüzgar enerji santralları çok fazla gürültü yapıyor, görüntü kirliliği yaratıyor ve kuşlar için de ölüm tuzağı görevini görüyorlar. Dahası rüzga...
Araştırmalar Covid enfeksiyonundan sonra antikor sayısının göreceli olarak hızlı bir şekilde azaldığını gösteriyor. Ama bu yine de kişinin hastalıktan daha az korunduğu anlamına gelmiyor. Çünkü son bir araştırmaya göre T-hücreleri kalıcı oluyor ve uzun vadeli bağışıklık üzerinde önemli bir rol oynuyorlar. Bağışıklık sistemi koronavirüsle iki şekilde mücadele ediyor: Antikorlarla veya T-hücreleriyl...